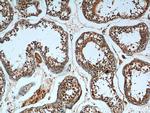
CCDC68 Antibody in Immunohistochemistry (Paraffin) (IHC (P))

Search
Proteintech
CCDC68 Polyclonal Antibody
{{$productOrderCtrl.translations['antibody.pdp.commerceCard.promotion.promotions']}}
{{$productOrderCtrl.translations['antibody.pdp.commerceCard.promotion.viewpromo']}}
{{$productOrderCtrl.translations['antibody.pdp.commerceCard.promotion.promocode']}}: {{promo.promoCode}} {{promo.promoTitle}} {{promo.promoDescription}}. {{$productOrderCtrl.translations['antibody.pdp.commerceCard.promotion.learnmore']}}
产品信息
26301-1-AP
种属反应
宿主/亚型
分类
类型
抗原
偶联物
形式
浓度
规格
纯化类型
保存液
内含物
保存条件
运输条件
产品详细信息
Immunogen sequence: MTTVTVTTE IPPRDKMEDN SALYESTSAH IIEETEYVKK IRTTLQKIRT QMFKDEIRHD STNHKLDAKH CGNLQQGSDS EMDPSCCSLD LLMKKIKGKD LQLLEMNKEN EVLKIKLQAS REAGAAALRN VAQRLFENYQ TQSEEVRKKQ EDSKQLLQVN KLEKEQKLKQ HVENLNQVAE KLEEKHSQIT ELENLVQRME KEKRTLLERK LSLENKLLQL KSSATYGKSC QDLQREISIL QEQISHLQFV IHSQHQNLRS VIQEMEGLKN NLKEQDKRIE NLREKVNILE AQNKELKTQV ALSSETPRTK VSKAVSTSEL KTEGVSPYLM LIRLRK (1-335 aa encoded by B C029508)
靶标信息
Coiled-coil domain containing 68 (CCDC68) demonstrates a tumor-suppressive role in pancreatic ductal adenocarcinoma.
仅用于科研。不用于诊断过程。未经明确授权不得转售。
生物信息学
蛋白别名: Coiled-coil domain-containing protein 68; CTCL tumor antigen se57-1; CTCL-associated antigen se57-1; cutaneous T-cell lymphoma associated antigen; Cutaneous T-cell lymphoma-associated antigen se57-1; unnamed protein product
基因别名: CCDC68; SE57-1
UniProt ID: (Human) Q9H2F9
Entrez Gene ID: (Human) 80323